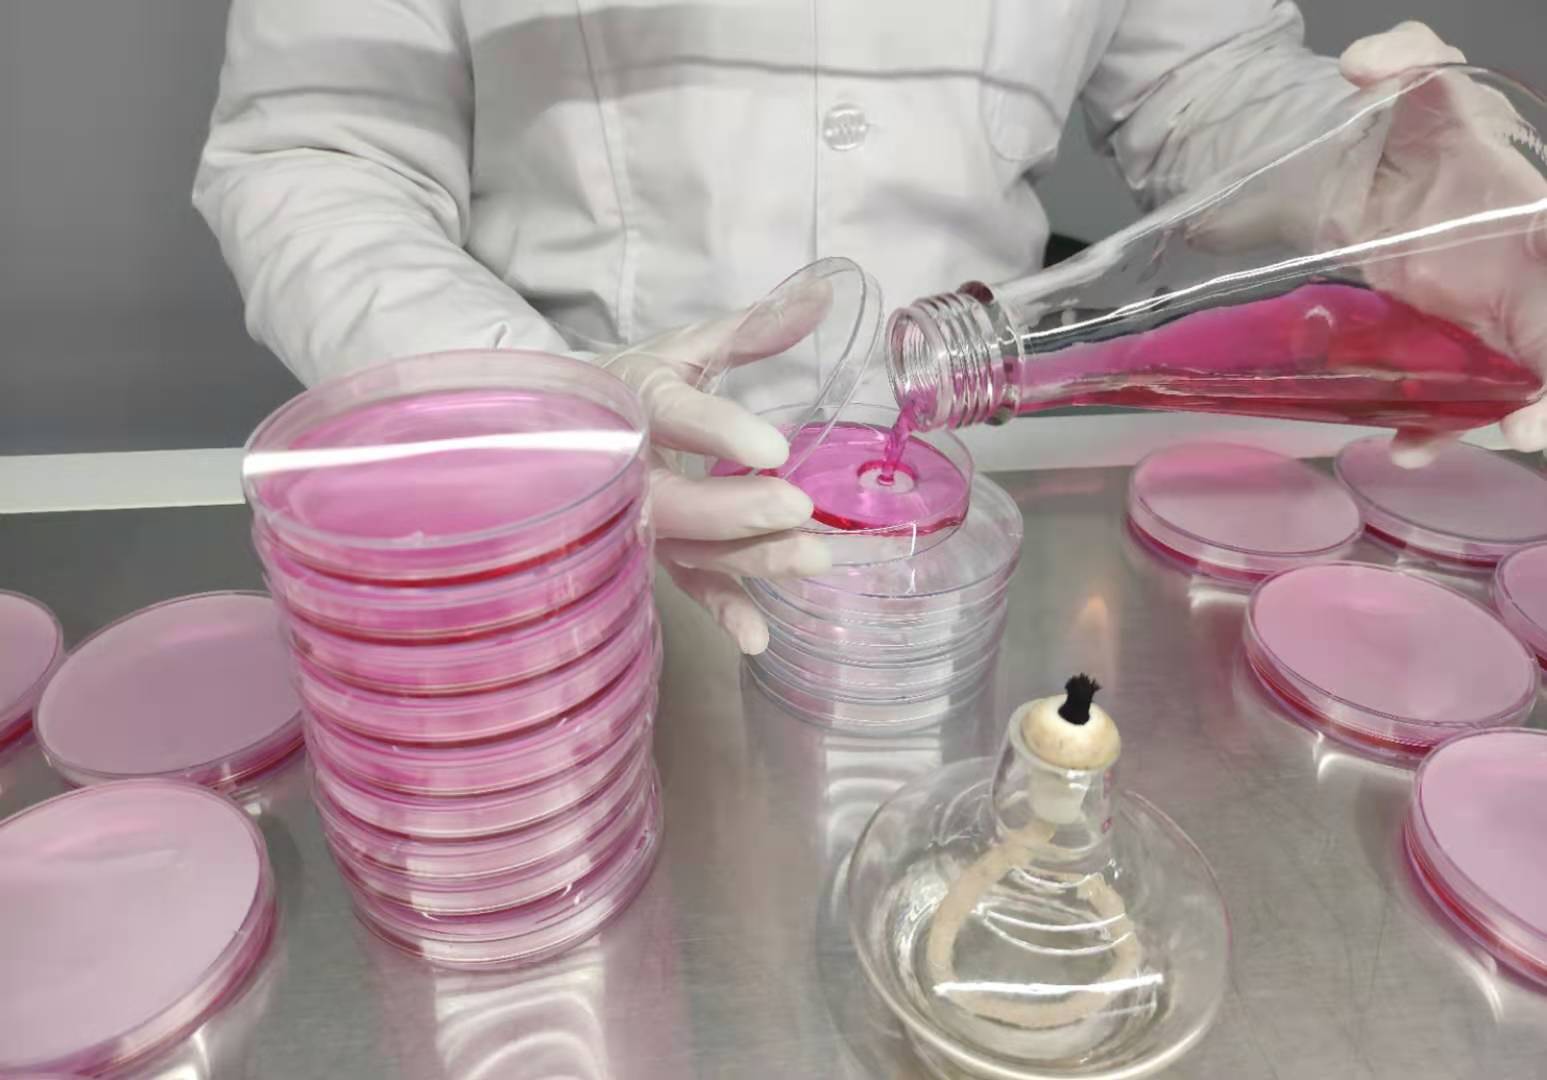
防腐防霉劑.jpg

簡愷生物是一家專注于防腐劑、防霉劑、抗菌劑等研發、生產、銷售及服務的一體化企業。因此簡愷技術部是重要部門之一,品檢課每個技術人員都具備團隊協作精神,認真嚴謹細心,具備良好的統計、實驗分析和解決問題的能力。嚴格按實驗室標準規范要求和培訓要求操作各項實驗,認真做好各個步驟的詳細實驗記錄;按時、保質、保量地完成實驗任務并按照公司格式要求,認真撰寫實驗報告。簡愷生物實驗員介紹如何規范配制營養瓊脂。
配制營養瓊脂目的
規范營養瓊脂培養基配制的操作規程。
原理
培養基含有氮源、碳源和微量無機鹽,適應細菌的生長繁殖。
用途
供細菌培養、菌株純化及傳種使用。
配方
營養瓊干粉(陸橋)33克、蒸餾水1000ml
操作步驟
稱取營養瓊干粉(陸橋)33克溶于1000ml蒸餾水中,混均至完全溶解分裝,經121℃滅菌15min,冷藏備用。
儲存條件
冰箱:2~8℃
以上是配制營養瓊脂的操作規程。簡愷生物作為研發生產防腐防霉劑廠家,很多實驗都需要用到營養瓊脂并在實驗中起到關鍵的環節。因此規范配制營養瓊脂是簡愷實驗室人員最基本和最重要掌握的實驗。
【本文標簽】 防腐劑
【責任編輯】